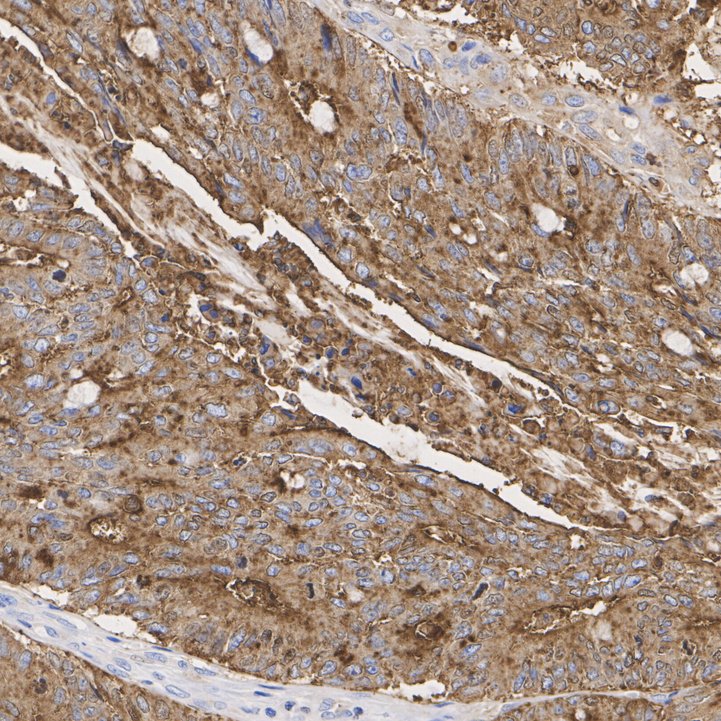

Carcino Embryonic Antigen CEA Recombinant Rabbit Monoclonal Antibody [JM93-28] - BSA and Azide free
Catalog# HA750434
Carcino Embryonic Antigen CEA Recombinant Rabbit Monoclonal Antibody [JM93-28] - BSA and Azide free
Application
-
WB
-
IF-Cell
-
IF-Tissue
-
IHC-P
Reactivity
-
Human
With BSA and Azide
-
ET1705-52
含抗保成分
Conjugation
-
unconjugated

浙公网安备 33019202000643号
浙公网安备 33019202000643号